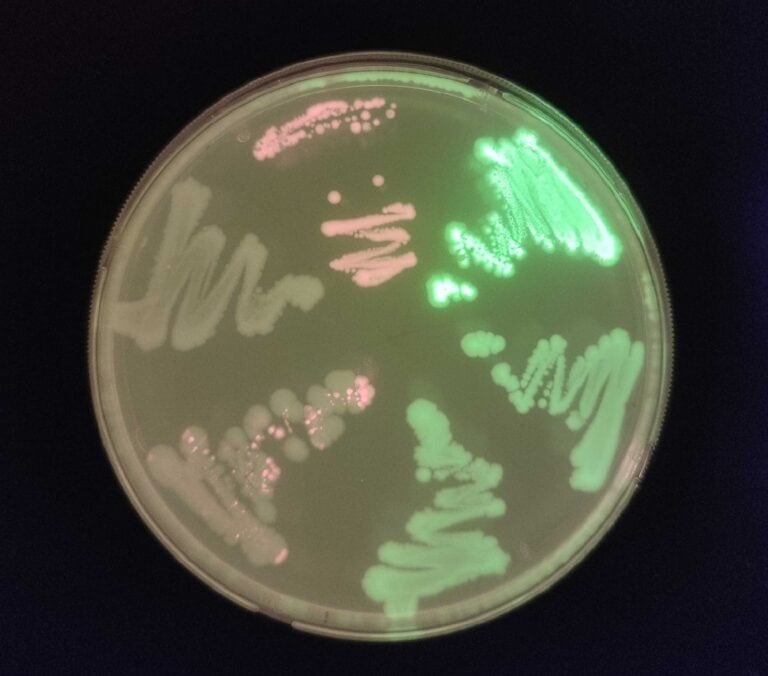

Researchers in Israel have announced a breakthrough in safely detecting landmines – using bacteria.
They’ve developed tiny pellet-sized biosensors based on E. coli – better known as the cause intestinal infections.
The biosensors are dispersed over the target area, where they sniff out the chemical signature of buried explosives and become luminescent.
A drone then flies over, photographs them, and reveals the location of any landmine.
“This project marks a breakthrough in the field of landmine detection,” said Gideon Lapidoth, CEO of Enzymit, a Ness Ziona-based startup mainly focused on developing a cell-free production platform for cultivated meat and breastmilk.
“This new biosensor is a game changer. It can be cheaply deployed anywhere in the world to safely detect a variety of hidden explosives and do so more accurately than current alternatives,” Lapidoth said, adding that the genetically engineered properties of E. coli causes the bacterium to die out shortly after deployment, ensuring it does not pose any human or environmental risk.
The biosensor “demonstrates the incredible potential of harnessing the synergy between synthetic biology and AI for a future where humanitarian and environmental challenges can be met with safe and sustainable solutions.”
110 million landmines
The planet is currently littered with an estimated 110 million landmines, many of them left over from wars that ended decades ago.
Landmines kill or maim 5,000 people a year. Detecting and removing them remains a dangerous business, despite attempts to use robots, drones, dogs and even bees instead of humans with metal detectors and probes.
The biosensors can detect trace amounts of an organic compound that is produced by TNT explosives and leaks out into the surrounding earth.
Enzymit worked with researchers from Prof. Shimshon Belkin’s Environmental Microbiology and Biosensor Laboratory at the Hebrew University of Jerusalem, and published its research in the peer-reviewed Computational and Structural Biotechnology Journal.
“The global proliferation of landmines continues to pose a serious threat to human lives and the environment, while traditional methods for detection are costly, time-consuming, and entail substantial risk to life,” said Belkin.
“This collaboration highlights the potential of synthetic biology in solving some of the world’s most pressing problems, with applications that go beyond landmine detection.”
From a safe distance
The E. coli-based biosensors can accurately locate unexploded ordnance from a distance, he said, providing a safer and more efficient alternative.

Lapidoth said: “Despite almost three decades having passed since the Ottawa Treaty, the global prevalence of antipersonnel mines and ERWs [explosive remnants of war] continues to present a clear and present danger to human life, with around 42% of those killed or wounded each year being children.
“The countries most affected by landmines often suffer a chronic shortage of adequate detection resources, relying on metal detectors and handheld probes, making the removal of landmines a dangerous, costly, and time-consuming process.”
The biosensors will first be deployed “in a limited operational capacity (not civilian) within the next year,” the company announced.
The research team is now working on adapting the biosensor to detect other forms of explosives, environmental toxins and hazardous chemicals.